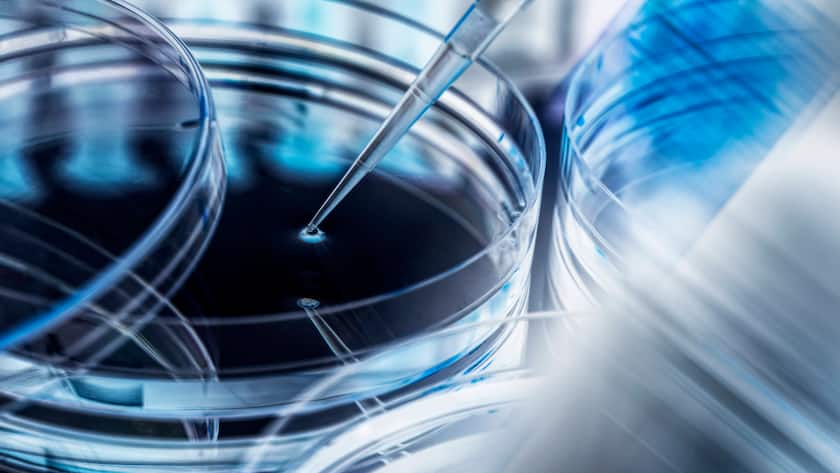
Pipettier-Einheit bei einem Biotechnologie-Unternehmen.

Durch die Patenterteilung wird die firmeneigene Rifabutin-IV-Formulierungstechnologie in dem Land geschützt.
Dem Antibiotikum wurde das Patent in mehr als 25 Ländern erteilt, erklärte Bioversys am Montag in einem Communiqué. Die Erweiterung der Patentabdeckung um China sei aufgrund der absoluten Zahl der Acinetobacter-Infektionen in den Land von «entscheidender» Bedeutung.
Das erlaube dem Unternehmen, China in eine Phase-III-Zulassungsstudie einzubeziehen, deren Start für das zweite Halbjahr 2025 geplant sei. Inklusive China rechne Bioversys mit einem Spitzenumsatzpotenzial von 800 Millionen US-Dollar.
(AWP)